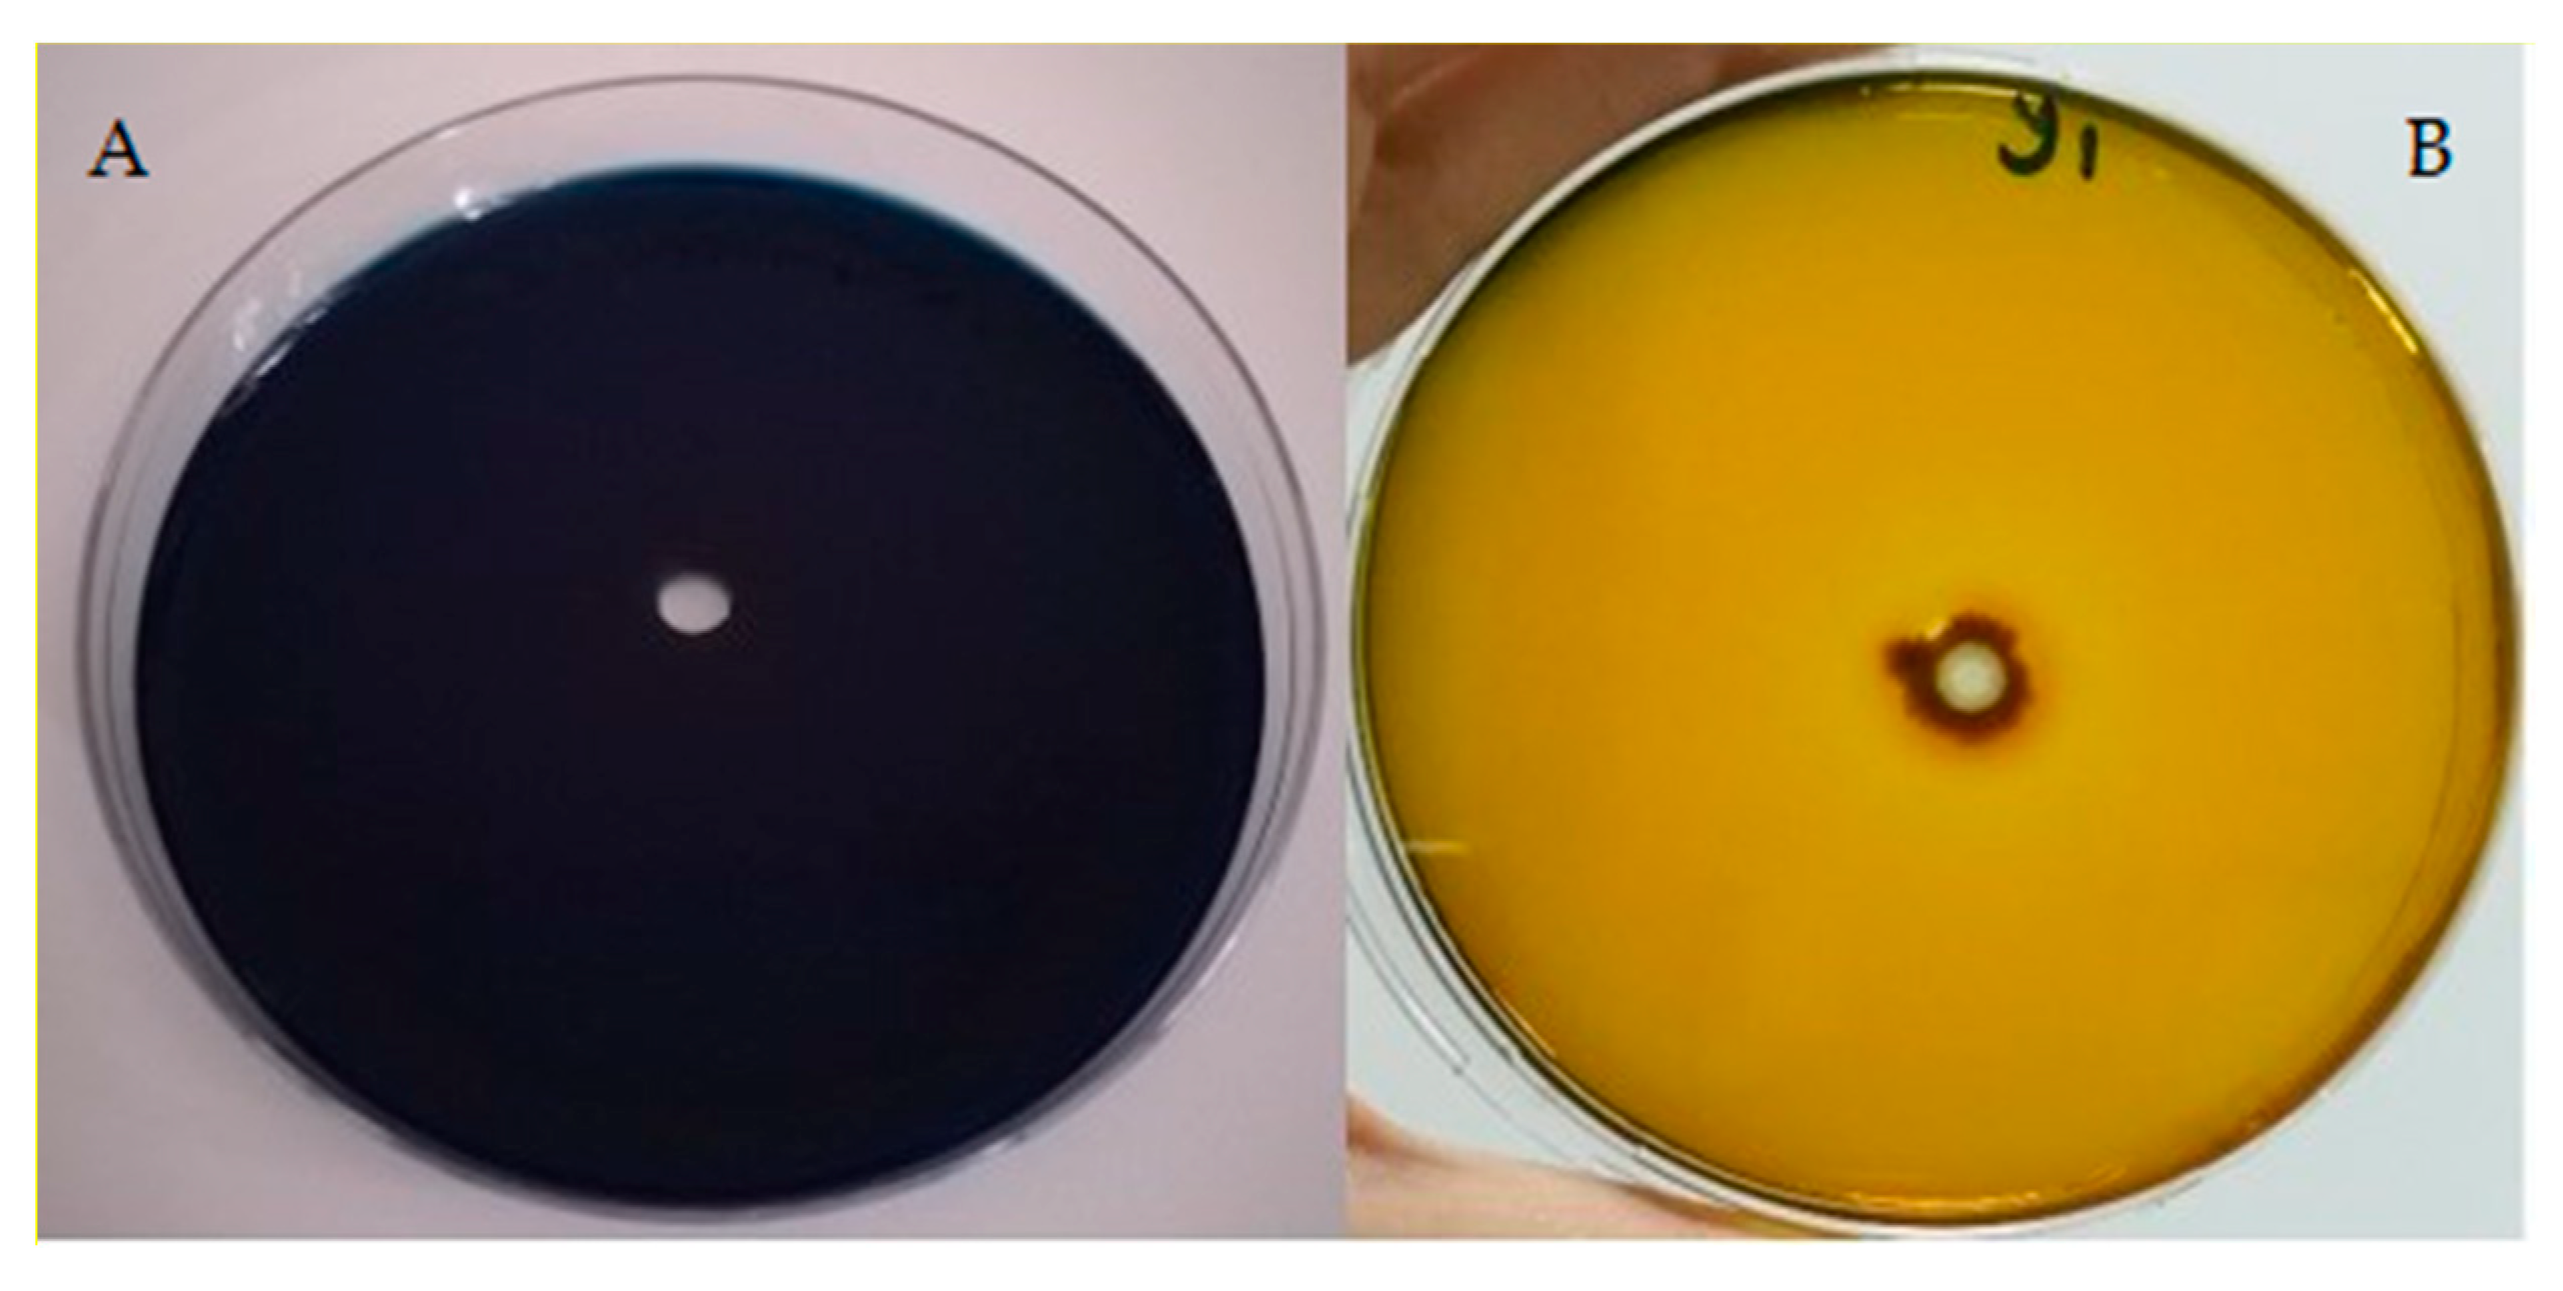
Fermentation 08 00731 g001

Citric Acid Production by Yarrowia lipolytica NRRL Y-1094: Optimization of pH, Fermentation Time and Glucose Concentration Using Response Surface Methodology
Abstract
1. Introduction
2. Materials and Methods
2.1. Microorganism
2.2. Fermentation Medium
2.3. Screening of Y. lipolytica Strains for Acid Production Capacities
2.4. Chemicals
2.5. Cultivation Conditions
2.6. Determination of CA and ICA Concentrations
2.7. Determination of Biomass and pH
2.8. Yield Calculations
- ➢
- CA yield on biomass: YCA/X (g/g);
- ➢
- Volumetric yield: YCA/t (g/L h);
- ➢
- Specific product-formation rate (qCA) = CA/(X.t) (g/g h);
- ➢
- Bioprocess selectivity: SCA (%) = (100 × CAT)/(CAT + ICAT).
2.9. Experimental Design
3. Results and Discussion
3.1. Selection of CA Producer Strain
3.2. Results of Experimental Design
3.3. Optimization of CA Production by Y. lipolytica NRRL Y-1094
4. Conclusions
Author Contributions
Funding
Institutional Review Board Statement
Informed Consent Statement
Data Availability Statement
Acknowledgments
Conflicts of Interest
Abbreviations
References
- Nayak, A.; Bhushan, B. An overview of the recent trends on the waste valorization techniques for food wastes. J. Environ. Manag. 2019, 233, 352–370. [Google Scholar] [CrossRef] [PubMed]
- Karaffa, L.; Kubicek, C.P. Citric acid and itaconic acid accumulation: Variations of the same story? Appl. Microbiol. Biotechnol. 2019, 103, 2889–2902. [Google Scholar] [CrossRef] [PubMed]
- Adeoye, A.O.; Lateef, A.; Gueguim-Kana, E.B. Optimization of citric acid production using a mutant strain of Aspergillus niger on cassava peel substrate. Biocatal. Agric. Biotechnol. 2015, 4, 568–574. [Google Scholar] [CrossRef]
- Singh Dhillon, G.; Kaur Brar, S.; Verma, M.; Tyagi, R.D. Recent advances in citric acid bio-production and recovery. Food Bioprocess Technol. 2011, 4, 505–529. [Google Scholar] [CrossRef]
- Cavallo, E.; Charreau, H.; Cerrutti, P.; Foresti, M.L. Yarrowia lipolytica: A model yeast for citric acid production. FEMS Yeast Res. 2017, 17, fox084. [Google Scholar] [CrossRef]
- Hu, W.; Li, W.J.; Yang, H.Q.; Chen, J.H. Current strategies and future prospects for enhancing microbial production of citric acid. Appl. Microbiol. Biotechnol. 2019, 103, 201–209. [Google Scholar] [CrossRef]
- Hesham, A.E.L.; Mostafa, Y.S.; AlSharqi, L.E.O. Optimization of citric acid production by immobilized cells of novel yeast isolates. Mycobiology 2020, 48, 122–132. [Google Scholar] [CrossRef]
- Holz, M.; Förster, A.; Mauersberger, S.; Barth, G. Aconitase overexpression changes the product ratio of citric acid production by Yarrowia lipolytica. Appl. Microbiol. Biotechnol. 2009, 81, 1087–1096. [Google Scholar] [CrossRef]
- Fickers, P.; Cheng, H.; Sze Ki Lin, C. Sugar alcohols and organic acids synthesis in Yarrowia lipolytica: Where are we? Microorganisms 2020, 8, 574. [Google Scholar] [CrossRef]
- Napitupulu, T.P.; Kanti, A.; Purnaningsih, I.; Sudiana, I.M. Comparison of addition mold and yeast inoculants on the production of citric acid in liquid and solid media from sorghum. IOP Conf. Ser. Earth Environ. Sci. 2020, 439, 012038. [Google Scholar] [CrossRef]
- Antonucci, S.; Bravi, M.; Bubbico, R.; Di Michele, A.; Verdone, N. Selectivity in citric acid production by Yarrowia lipolytica. Enzym. Microb. Technol. 2001, 2, 189–195. [Google Scholar] [CrossRef] [PubMed]
- Baş, D.; Boyacı, I.H. Modeling and optimization I: Usability of response surface methodology. J. Food Eng. 2007, 7, 836–845. [Google Scholar] [CrossRef]
- Crolla, A.; Kennedy, K.J. Optimization of citric acid production from Candida lipolytica Y-1095 using n-paraffin. J. Biotechnol. 2001, 89, 27–40. [Google Scholar] [CrossRef] [PubMed]
- Rymowicz, W.; Cibis, E. Optimization of citric acid production from glucose syrup by Yarrowia lipolytica using response surface methodology. Electron. J. Pol. Agric. Univ. Ser. Biotechnol. 2006, 9. [Google Scholar]
- Imandi, S.B.; Bandaru, V.R.; Somalanka, S.R.; Garapati, H.R. Optimization of medium constituents for the production of citric acid from byproduct glycerol using Doehlert experimental design. Enzym. Microb. Technol. 2007, 40, 1367–1372. [Google Scholar] [CrossRef]
- Imandi, S.B.; Bandaru, V.V.R.; Somalanka, S.R.; Bandaru, S.R.; Garapati, H.R. Application of statistical experimental designs for the optimization of medium constituents for the production of citric acid from pineapple waste. Bioresour. Technol. 2008, 99, 4445–4450. [Google Scholar] [CrossRef] [PubMed]
- Urak, S.; Yeniay, O.; Karasu-Yalcin, S. Optimization of citric acid production from a carrot juice-based medium by Yarrowia lipolytica using response surface methodology. Ann. Microbiol. 2015, 65, 639–649. [Google Scholar] [CrossRef]
- Avila Neto, P.M.; da Silva, G.P.; Lima, C.J.B.; De Paula, F.C.; Contiero, J. Evaluation and optimization of growth and citric acid production by Yarrowia lipolytica NRRL Y-1095 using glycerol as carbon source as an alternative to use biodiesel byproduct. J. Exp. Biol. Agric. Sci. 2014, 2, 25–31. [Google Scholar]
- Giacomobono, R.; Albergo, R.; Valerio, V.; Caporusso, A.; De Bari, I. Modelling of the citric acid production from crude glycerol by wild-type Yarrowia lipolytica DSM 8218 using response surface methodology (RSM). Life 2022, 12, 621. [Google Scholar] [CrossRef]
- Carly, F.; Vandermies, M.; Telek, S.; Steels, S.; Thomas, S.; Nicaud, J.M.; Fickers, P. Enhancing erythritol productivity in Yarrowia lipolytica using metabolic engineering. Metab. Eng. 2017, 42, 19–24. [Google Scholar] [CrossRef]
- Kamzolova, S.V.; Finogenova, T.V.; Morgunov, I.G. Microbiological production of citric and isocitric acids from sunflower oil. Food Technol. Biotechnol. 2008, 46, 51–59. [Google Scholar]
- Makri, A.; Fakas, S.; Aggelis, G. Metabolic activities of biotechnological interest in Yarrowia lipolytica grown on glycerol in repeated batch cultures. Bioresour. Technol. 2010, 101, 2351–2358. [Google Scholar] [CrossRef] [PubMed]
- Morgunov, I.G.; Kamzolova, S.V.; Lunina, J.N. The citric acid production from raw glycerol by Yarrowia lipolytica yeast and its regulation. Appl. Microbiol. Biotechnol. 2013, 97, 7387–7397. [Google Scholar] [CrossRef]
- Sabra, W.; Bommareddy, R.R.; Maheshwari, G.; Papanikolaou, S.; Zeng, A.P. Substrates and oxygen dependent citric acid production by Yarrowia lipolytica: Insights through transcriptome and fluxome analyses. Microb. Cell Fact. 2017, 16, 78. [Google Scholar] [CrossRef]
- Kamzolova, S.V.; Shamin, R.V.; Stepanova, N.N.; Morgunov, G.I.; Lunina, J.N.; Allayarov, R.K.; Samoilenko, V.A.; Morgunov, I.G. Fermentation conditions and media optimization for isocitric acid production from ethanol by Yarrowia lipolytica. BioMed Res. Int. 2018, 2018, 2543210. [Google Scholar] [CrossRef]
- Zhang, S.; Jagtap, S.S.; Deewan, A.; Rao, C.V. pH selectively regulates citric acid and lipid production in Yarrowia lipolytica W29 during nitrogen-limited growth on glucose. J. Biotechnol. 2019, 290, 10–15. [Google Scholar] [CrossRef] [PubMed]
- Levinson, W.E.; Kurtzman, C.P.; Kuo, T.M. Characterization of Yarrowia lipolytica and related species for citric acid production from glycerol. Enzym. Microb. Technol. 2007, 41, 292–295. [Google Scholar] [CrossRef]
- Rane, K.D.; Sims, K.A. Production of citric acid by Candida lipolytica Y1095: Effect of glucose concentration on yield and productivity. Enzym. Microb. Technol. 1993, 15, 646–651. [Google Scholar] [CrossRef]
- Papanikolaou, S.; Aggelis, G. Lipid production by Yarrowia lipolytica growing on industrial glycerol in a single-stage continuous culture. Bioresour. Technol. 2002, 82, 43–49. [Google Scholar] [CrossRef]
- Celik, G.; Uçar, F.; Akpinar, O.; Corbaci, C. Production of citric and isocitric acid by Yarrowia lipolytica strains grown on different carbon sources. Turk. J. Biochem. 2014, 39, 285–290. [Google Scholar] [CrossRef]
- Kamzolova, S.V.; Morgunov, I.G. Metabolic peculiarities of the citric acid overproduction from glucose in yeasts Yarrowia lipolytica. Bioresour. Technol. 2017, 243, 433–440. [Google Scholar] [CrossRef] [PubMed]
- Yalcin, S.K.; Bozdemir, M.T.; Ozbas, Z.Y. Citric acid production by yeasts: Fermentation conditions, process optimization and strain improvement. Curr. Res. Technol. Educ. Top. Appl. Microbiol. Microb. Biotechnol. 2010, 9, 1374–1382. [Google Scholar]
- Soccol, C.R.; Vandenberghe, L.P.; Rodrigues, C.; Pandey, A. New perspectives for citric acid production and application. Food Technol. Biotechnol. 2006, 44, 141–149. [Google Scholar]
- Souza, K.S.T.; Schwan, R.F.; Dias, D.R. Lipid and citric acid production by wild yeasts grown in glycerol. J. Microbiol. Biotechnol. 2014, 24, 497–506. [Google Scholar] [CrossRef]
- Papanikolaou, S.; Galiotou-Panayotou, M.; Chevalot, I.; Komaitis, M.; Marc, I.; Aggelis, G. Influence of glucose and saturated free-fatty acid mixtures on citric acid and lipid production by Yarrowia lipolytica. Curr. Microbiol. 2006, 52, 134–142. [Google Scholar] [CrossRef] [PubMed]
- Yalcin, S.K.; Bozdemir, M.T.; Ozbas, Z.Y. A comparative study on citric acid production kinetics of two Yarrowia lipolytica strains in two different media. Indian J. Biotechnol. 2009, 8, 408–417. [Google Scholar]
- Papanikolaou, S.; Chatzifragkou, A.; Fakas, S.; Galiotou-Panayotou, M.; Komaitis, M.; Nicaud, J.M.; Aggelis, G. Biosynthesis of lipids and organic acids by Yarrowia lipolytica strains cultivated on glucose. Eur. J. Lipid Sci. Technol. 2009, 111, 1221–1232. [Google Scholar] [CrossRef]
- Lazar, Z.; Walczak, E.; Robak, M. Simultaneous production of citric acid and invertase by Yarrowia lipolytica SUC+ transformants. Bioresour. Technol. 2011, 102, 6982–6989. [Google Scholar] [CrossRef]
- Carsanba, E.; Papanikolaou, S.; Fickers, P.; Erten, H. Screening various Yarrowia lipolytica strains for citric acid production. Yeast 2019, 36, 319–327. [Google Scholar] [CrossRef]
- Moeller, L.; Strehlitz, B.; Aurich, A.; Zehnsdorf, A.; Bley, T. Optimization of citric acid production from glucose by Yarrowia lipolytica. Eng. Life Sci. 2007, 7, 504–511. [Google Scholar] [CrossRef]
- Fu, G.Y.; Lu, Y.; Chi, Z.; Liu, G.L.; Zhao, S.F.; Jiang, H.; Chi, Z.M. Cloning and characterization of a pyruvate carboxylase gene from Penicillium rubens and overexpression of the genein the yeast Yarrowia lipolytica for enhanced citric acid production. Mar. Biotechnol. 2016, 18, 1–14. [Google Scholar] [CrossRef] [PubMed]

| Levels | ||||
|---|---|---|---|---|
| Factor | Independent Variables | −1 | 0 | +1 |
| X1 | Initial pH-value | 5.5 | 6.0 | 6.5 |
| X2 | Fermentation time (days) | 4 | 5 | 6 |
| X3 | Glucose concentration (g/L) | 125 | 150 | 175 |
| Microorganism | Day 1 | Day 2 | Day 3 | Day 4 | Day 5 | Day 6 |
|---|---|---|---|---|---|---|
| Y. lipolytica NRRL Y-1094 | 2.75 ± 0.35 | 7.50 ± 2.12 | 18.00 ± 2.83 | 23.00 ± 1.41 | 34.00 ± 0.00 | 35.00 ± 0.00 |
| Y. lipolytica IFP29 | 1.50 ± 0.71 | 4.00 ± 0.00 | 10.00 ± 1.41 | 19.00 ± 1.41 | 26.00 ± 1.41 | 30.00 ± 1.41 |
| Run | pH0 | Time (days) | Glucose Conc. (g/L) | CA (g/L) | ICA (g/L) | X (g/L) |
|---|---|---|---|---|---|---|
| 1 | 6.0 | 5 | 150 | 16.85 ± 1.00 | 2.62 ± 1.10 | 9.88 ± 0.35 |
| 2 | 6.5 | 6 | 175 | 24.30 ± 7.54 | 2.92 ± 1.34 | 12.27 ± 1.48 |
| 3 | 6.5 | 5 | 150 | 13.65 ± 0.62 | 1.47 ± 0.00 | 9.69 ± 0.06 |
| 4 | 5.5 | 5 | 150 | 16.52 ± 2.25 | 1.76 ± 0.69 | 10.20 ± 0.77 |
| 5 | 6.0 | 5 | 150 | 17.93 ± 3.94 | 2.49 ± 1.24 | 10.86 ± 1.40 |
| 6 | 6.0 | 5 | 150 | 17.04 ± 3.86 | 1.68 ± 0.24 | 9.71 ± 0.45 |
| 7 | 5.5 | 6 | 125 | 30.31 ± 0.47 | 5.57 ± 1.30 | 13.42 ± 0.33 |
| 8 | 6.0 | 5 | 150 | 16.27 ± 0.43 | 3.07 ± 0.32 | 11.53 ± 1.58 |
| 9 | 5.5 | 4 | 125 | 12.77 ± 0.06 | 2.52 ± 0.42 | 10.24 ± 0.86 |
| 10 | 6.0 | 4 | 150 | 8.87 ± 2.06 | 1.17 ± 0.25 | 9.25 ± 1.53 |
| 11 | 6.5 | 4 | 125 | 11.64 ± 0.67 | 2.64 ± 0.25 | 12.95 ± 2.98 |
| 12 | 5.5 | 4 | 175 | 11.91 ± 2.69 | 1.73 ± 0.23 | 8.77 ± 1.58 |
| 13 | 5.5 | 6 | 175 | 26.58 ± 2.06 | 3.03 ± 0.11 | 12.42 ± 0.98 |
| 14 | 6.0 | 5 | 175 | 21.40 ± 0.76 | 3.22 ± 0.03 | 11.32 ± 1.50 |
| 15 | 6.5 | 6 | 125 | 29.74 ± 1.82 | 5.38 ± 1.07 | 13.60 ± 0.63 |
| 16 | 6.0 | 5 | 150 | 16.96 ± 0.00 | 1.93 ± 0.11 | 11.83 ± 1.46 |
| 17 | 6.5 | 4 | 175 | 8.56 ± 2.17 | 1.08 ± 0.25 | 9.44 ± 0.45 |
| 18 | 6.0 | 6 | 150 | 26.03 ± 6.11 | 4.54 ± 1.64 | 12.86 ± 0.40 |
| 19 | 6.0 | 5 | 150 | 17.64 ± 0.01 | 4.04 ± 2.09 | 11.80 ± 0.65 |
| 20 | 6.0 | 5 | 125 | 25.36 ± 0.37 | 4.37 ± 0.66 | 12.15 ± 1.01 |
| Source | DF | Seq SS | Adj SS | Adj MS | F | p |
|---|---|---|---|---|---|---|
| Regression | 9 | 827.773 | 827.773 | 91.975 | 195.70 | 0.000 |
| Linear | 3 | 731.933 | 731.933 | 243.978 | 519.14 | 0.000 |
| Square | 3 | 90.158 | 90.158 | 30.053 | 63.95 | 0.000 |
| Interaction | 3 | 5.682 | 5.682 | 1.894 | 4.03 | 0.041 |
| Residual error | 10 | 4.700 | 4.700 | 0.470 | ||
| Lack of fit | 5 | 2.946 | 2.946 | 0.589 | 1.68 | 0.292 |
| Pure error | 5 | 1.754 | 1.754 | 0.351 | ||
| Total | 19 | 832.472 |
| Term | Coefficient | SE Coefficient | T | p |
|---|---|---|---|---|
| Constant | 17.436 | 0.236 | 73.99 | <0.001 |
| pH | −1.020 | 0.217 | −4.71 | 0.001 |
| Time | 8.321 | 0.217 | 38.38 | <0.001 |
| Glucose conc. | −1.707 | 0.217 | −7.87 | <0.001 |
| pH × pH | −2.833 | 0.413 | −6.85 | <0.001 |
| Time × Time | −0.468 | 0.413 | −1.13 | 0.284 |
| Glucose conc. × Glucose conc. | 5.462 | 0.413 | 13.21 | <0.001 |
| pH × Time | 0.204 | 0.242 | 0.84 | 0.420 |
| pH × Glucose conc. | −0.491 | 0.242 | −2.03 | 0.070 |
| Time × Glucose conc. | −0.654 | 0.242 | −2.70 | 0.022 |
Publisher’s Note: MDPI stays neutral with regard to jurisdictional claims in published maps and institutional affiliations. |
© 2022 by the authors. Licensee MDPI, Basel, Switzerland. This article is an open access article distributed under the terms and conditions of the Creative Commons Attribution (CC BY) license (https://creativecommons.org/licenses/by/4.0/).
Share and Cite
Sayın Börekçi, B.; Kaya, M.; Kaban, G. Citric Acid Production by Yarrowia lipolytica NRRL Y-1094: Optimization of pH, Fermentation Time and Glucose Concentration Using Response Surface Methodology. Fermentation 2022, 8, 731. https://doi.org/10.3390/fermentation8120731
Sayın Börekçi B, Kaya M, Kaban G. Citric Acid Production by Yarrowia lipolytica NRRL Y-1094: Optimization of pH, Fermentation Time and Glucose Concentration Using Response Surface Methodology. Fermentation. 2022; 8(12):731. https://doi.org/10.3390/fermentation8120731
Chicago/Turabian StyleSayın Börekçi, Bilge, Mükerrem Kaya, and Güzin Kaban. 2022. "Citric Acid Production by Yarrowia lipolytica NRRL Y-1094: Optimization of pH, Fermentation Time and Glucose Concentration Using Response Surface Methodology" Fermentation 8, no. 12: 731. https://doi.org/10.3390/fermentation8120731
APA StyleSayın Börekçi, B., Kaya, M., & Kaban, G. (2022). Citric Acid Production by Yarrowia lipolytica NRRL Y-1094: Optimization of pH, Fermentation Time and Glucose Concentration Using Response Surface Methodology. Fermentation, 8(12), 731. https://doi.org/10.3390/fermentation8120731

